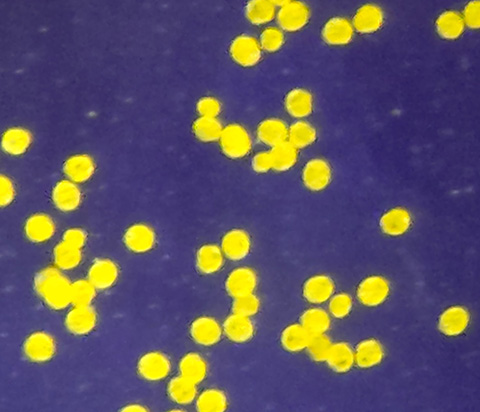

4月25日、今年度最初の生きものミニサロンを実施しました。テーマは「タンポポ博士になろう!」です。今、花まっさかりのタンポポですが、じつはいろいろと奥深い植物です。

博物館前庭のカントウタンポポ群落
まずは、館内でタンポポの特徴を確認します。花の茎が枝分かれせず(1本の茎に1つの花)、茎の途中から葉が出ない(すべての葉は地面から生える)のがタンポポの特徴です。

写真でタンポポの特徴を確認 よく似たオオジシバリがタンポポではないことをしっかり見つけてくれました
しっかり特徴を確認してくれたので、外へ出て、もともと日本に分布していた在来種(カントウタンポポ)を探します。

カントウタンポポの特徴を確認
花を支える部分(総苞:そうほう)がしっかりまとまっているのがカントウタンポポです。じつは、一番最初の写真もカントウタンポポで、博物館の前庭の様子です。ここ2、3年でカントウタンポポが分布を広げてきたことは、先日このブログにも書きました。

カントウタンポポの花
続いて駐車場へ移動して、雑種のタンポポを探します。雑種の見た目はカントウタンポポに似ていますが、総苞をよく見ると、まとまりが悪いのがわかります。

総苞のまとまりが悪い雑種のタンポポ
それを確認しながら、花粉を採取します。

花粉をセロハンテープにくっつけます
駐車場の奥に用意した顕微鏡で観察。

顕微鏡で花粉を観察
まず雑種の花粉を見て、大きさが揃っていないことを確認してから、カントウタンポポの花粉を観察すると、つぶのそろい方に「わぁ!」と声をあげて驚いてくれたお子さんも。

たくさんの花粉のつぶの大きさが揃っていて感激!
こちらは、スマートフォンに着けて撮影できる顕微鏡レンズで撮影したものです。

カントウタンポポの花粉 つぶの大きさがそろっている
雑種の花粉はよく見ると、小さいものや大きなものが混じっている
参加者のみなさんにも実際に撮影してもらいました。
同じような見た目なのに、顕微鏡で見るとはっきり違いをわかることが新鮮だったようです。最後に「こんな観察したね」カードを配布して終了しました。
野外で快適に過ごせる季節になり、今年度最初のミニサロンを楽しく実施できました。
次回は5月16日(土)12時からです。
(博物館長・学芸員)


